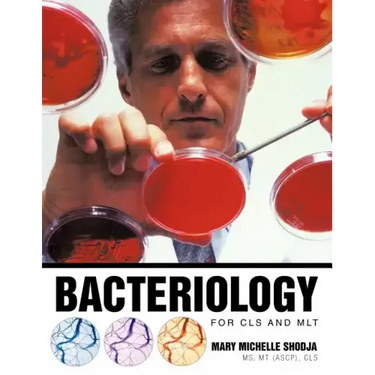

Bacteriology for Cls and Mlt - Paperback
Bacteriology for Cls and Mlt - Paperback
$65.32
/

products.product.pickup_availability.unavailable
Your payment information is processed securely. We do not store credit card details nor have access to your credit card information.
by Mary Michelle Shodja Mt (Ascp) Cls (Author)
A manual specifically designed for a MLT Training Program that had been tried and tested by a California Laboratory.
Added information makes this manual a perfect reviewer for CLSs planning to take their certification or licensure. A manual that will boost confidence to those CLSs who had been away from the micro bench. A good continuing education material to satisfy the requirement for CLS or MLT license renewal.